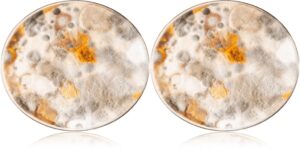

home mold test kits
Business
Is Your Home Making You Sick? Why a Home Mold Test Kit Is the First Step
That feeling of persistent, unexplained illness, the kind where you just don’t feel “right” anymore, can be terrifying. You’ve been to the doctor, and everything comes back normal, yet the daily pressure headaches, brain fog, and crushing fatigue won’t lift. If this sounds familiar, the source of your symptoms might be hiding in plain sight: […]
Read More
Business
Attic Attack: Uncovering Hidden Mold Growth in Upper Levels
Your attic: a treasure trove of forgotten holiday decorations, childhood mementos, and maybe even a dusty board game or two. But beyond the nostalgia, your attic can also harbor a hidden enemy – mold. Mold spores thrive in warm, damp environments, and attics – often poorly ventilated and prone to condensation – can become breeding […]
Read More